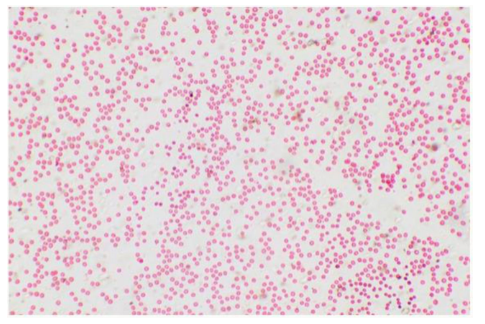

Олимпиада онлайн Сириус Биология ответы ВСОШ школьный этап 7-11 класс. Решили все задания для 7, 8, 9, 10, 11 класса Сириус олимпиада по биологии правильные ответы для школьного этапа 2025-2026 учебный год всероссийской олимпиады школьников ВСОШ 3 группа регионов дата проведения 10 октября 2025 начало олимпиады в 08:00 утра.
Олимпиада 7 класс Биология ответы
1. Процесс, изображённый на рисунке, происходит на уровне организации живого

Ответ: клеточном
2. Что общего у клеток, изображённых на рисунке?

Наличие клеточной стенки
Наличие пластид
Химизм клеточной стенки
Запасное вещество
Ответ: наличие клеточной стенки
3. Семиклассники посетили деревообрабатывающее предприятие, где увидели необычный спил дерева. Рассматривая его, Михаил отметил, что у спила лишь немного повреждена кора. Марина утверждала, что кора — самый толстый слой на этом спиле. Маша предположила, что спиленному дереву было более 17 лет. Максим сказал, что на спиле видны две сердцевины, потому что срослись два отдельных ствола. Кто из ребят прав?

Михаил
Маша
Марина
Максим
Ответ: Максим
4. Какой из изображённых способов вегетативного размножения растений НЕ встречается в естественной природной среде?

Ответ: 1 картинка
5. Для исследования влияния окружающей среды на процесс фотосинтеза учёные провели научный эксперимент. В специально оборудованной герметичной теплице были размещены растения томата сорта «Флора». Исследователи изменяли количество углекислого газа в воздухе теплицы и с помощью датчиков отслеживали, как меняется скорость фотосинтеза при различных концентрациях углекислого газа. Результат представлен на графике. Какой вывод можно сделать из этого графика?

Скорость фотосинтеза всегда линейно зависит от концентрации углекислого газа
Фотосинтез растений протекает на свету
При концентрации углекислого газа более 0.1% фотосинтез ускоряется
Скорость фотосинтеза достигает максимального значения
при концентрации углекислого газа, равной 0.1%
Ответ: Скорость фотосинтеза достигает максимального значения
при концентрации углекислого газа, равной 0.1%
6. В семенах могут запасаться различные питательные вещества, необходимые для прорастания и начального роста растений. В семени какого растения содержится больше всего углеводов?

Ответ: подсолнечник
7. Одним из важных механизмов адаптации растений к изменяющимся условиям окружающей среды является видоизменение их органов. Благодаря этим изменениям растения не только сохраняют свои основные функции, но и получают дополнительные возможности для выживания, размножения и успешного существования в конкретных природных условиях. Видоизменением какого органа является обозначенная на рисунке структура?

Прилистника
Листа
Стебля
Околоцветника
Ответ: прилистника
8. В лаборатории селекции растений вывели новый сорт декоративного растения. Известно, что его цветок имеет следующие характеристики: околоцветник состоит из шести свободных лепестков, расположенных в два круга по 3 лепестка; тычинок шесть, они свободные, размещены в два круга по 3 тычинки в каждом; гинецей один, состоящий из трёх сросшихся плодолистиков. Какая диаграмма цветка подходит под это описание?

Ответ: 1 изображение
9. Жизненные циклы растений сильно различаются в зависимости от вида и экологических стратегий. Некоторые растения адаптировались к быстрому прохождению цикла — за короткий вегетационный период. Другие, напротив, реализуют свои жизненные функции в течение нескольких лет или даже столетий. Какое растение завершит свой жизненный цикл быстрее остальных?

Ответ: морковь
10. Выберите верное утверждение о представленных растениях:

Растение В имеет дихотомическое ветвление
У растения Гот корневища отходят боковые корни
Растение А не имеет корней
У растения Б спороносные колоски образуются осенью
Ответ: Растение В имеет дихотомическое ветвление
11. Охарактеризуйте гаметофит изображённого растения:

Имеет архегонии и антеридии
Имеет антеридии, не имеет архегониев
Имеет архегонии, не имеет антеридиев
Не имеет архегониев и антеридиев
Ответ: имеет архегонии и антеридии
12. В каких отношениях с таксономической точки зрения находятся горчица белая и люпин белый?
Относятся к одному семейству
Относятся к разным классам одного отдела
Относятся к разным семействам одного класса
Относятся к разным отделам
Ответ: относятся к разным классам одного отдела
13. Укус изображенного животного несёт угрозу здоровью человека. Почему?

Укус вызывает сильную кровопотерю
Укус вызывает отравление сильным ядом
Животное является переносчиком опасного заболевания
Животное является возбудителем опасного заболевания
Ответ: животное является переносчиком опасного заболевания
14. Алексей с папой вернулись с удачной рыбалки. Пойманный ими окунь оказался таким крупным, что мальчик заинтересовался — сколько же лет этой рыбе? Что поможет Алексею определить возраст окуня?

Зубы
Чешуя
Количество тёмных поперечных полос на туловище
Количество лучей в плавнике
Ответ: количество тёмных поперечных полос на туловище
15. В организме человека различные органы, объединяясь, образуют системы, которые совместно осуществляют важные функции жизнедеятельности. Какая система органов отвечает за транспорт веществ в организме человека?
Ответ: нижнее правое
16. На рисунке изображён жизненный цикл шляпочного гриба мухомора. Выберите верные утверждения:

Плодовое тело гриба имеет общее и частное покрывала
Споры гриба одноядерные
Клетки самой продолжительной стадии жизненного цикла содержат два ядра
Это трубчатый гриб
Плодовое тело формируется на одноядерном мицелии
Ответ: 2, 3, 5
17. Какие функции выполняет структура, обозначенная стрелкой?

Снижения трения
Защитную
Проведения
Ориентации в пространстве
Всасывания
Ответ: Защитную
18. Без картофеля сложно представить традиционную русскую кухню. Появление его в нашей стране часто связывают с эпохой Петра І. Выберите верные утверждения о картофеле:
Плод картофеля — ягода
Родина картофеля — Южная Америка, в Россию его привезли в XVII веке
Цветки картофеля собраны в соцветие зонтик
Клубни картофеля находятся под землёй на корнях растения
Клубни — не единственные видоизменённые побеги, которые можно обнаружить у картофеля

19. Листья растений поражают своим многообразием: они могут иметь различную форму, размеры, особенности края пластинки и способы прикрепления к стеблю. Такая вариативность — результат приспособления к разным условиям среды. Выберите простые листья:
Получить ответы на все задания

20. Позвоночные животные демонстрируют поразительную способность к адаптации, заселяя практически все возможные местообитания на нашей планете — от океанских глубин до высокогорных вершин, от знойных пустынь до заснеженных тундр. Какие пути адаптации помогают им активно жить при низких температурах окружающей среды?
Спячка
Повышение интенсивности обмена веществ
Миграция
Снижение температуры тела
Усиление теплоизоляции организма
Получить ответы на все задания
21. Учащиеся биологического кружка изучали анатомические препараты поперечных срезов органов высших растений. После занятия дежурный собрал все микропрепараты вместе и случайно перепутал их. Установите соответствие между представленными гистологическими срезами и органами, которым они принадлежат.
Получить ответы на все задания
Олимпиада 8 класс Биология ответы
1. Издавна на Руси мастерили скворечники, привлекая птиц для борьбы с насекомыми-вредителями. Опытным путём были выработаны оптимальные параметры домика для птиц. Почему размер входного отверстия (летка) в скворечнике делают небольшим?

Чтобы в скворечник не затекала дождевая вода
Чтобы птенцы не выпали из гнезда, пока не научатся летать
Чтобы крупные хищники не могли проникнуть внутрь и разорить гнездо
Чтобы взрослые птицы кормили птенцов по очереди, так как вдвоём не смогут попасть в скворечник
Ответ: чтобы крупные хищники не могли проникнуть внутрь и разорить гнездо
2. Оля любит по утрам делать омлет и знает, что яйцо — это ценный и полезный пищевой продукт. Каких компонентов в яйце меньше всего?
Жиров
Воды
Белков
Углеводов
Ответ: Жиров
3. На занятии ребята рассматривали под микроскопом микропрепарат. Данияр предположил, что данная ткань обладает выраженной клеточной организацией, Андрей сказал, что на препарате виден центральный канал, вокруг которого располагается серое вещество. Лена отметила, что белое вещество расположено в центре в форме бабочки и содержит тела нейронов и дендриты, а Яна считает, что белое вещество, занимающее большую часть объёма препарата, состоит из отростков нейронов и образует проводящие пути. Кто из ребят НЕ прав?

Андрей
Лена
Данияр
Яна
Ответ: Яна
4. В систематике жуков (отряд Coleoptera) много необычных и ярких названий. Какое название таксономической группы НЕ относится к реально существующим среди жуков?
Жуки-отшельники
Жуки-скакуны
Жуки-монархи
Жуки-голиафы
Ответ: Жуки-отшельники
5. Выберите верное утверждение об изображённых насекомых:

Оба насекомых развиваются с полным превращением
Оба насекомых относятся к одному отряду
Насекомое с жалом это самка, а насекомое с церками — самец
Насекомые имеют по две пары крыльев
Ответ: Оба насекомых развиваются с полным превращением
6. Паутина паука-кругопряда славится не только своей прочностью, но и эластичностью, то есть способностью растягиваться до 20-30% от своей длины и возвращаться в исходное состояние не разрываясь. Какой тип паутинных нитей в большей степени отвечает за данное свойство?

Нити рамы (рамочные нити)
Радиальные нити (радиусы)
Нити ловчей спирали
Аксиальные нити кокона
Ответ: Нити ловчей спирали
7. Выберите утверждение, верное для всех изображённых червей:

Имеют сквозную пищеварительную систему
Являются опасными паразитами человека
Относятся к трехслойным животным
Являются гермафродитами
Ответ: имеют сквозную пищеварительную систему
8. Чернильная железа есть у головоногих моллюсков, например, у осьминога или каракатицы. Что произойдёт с организмом хищника, который проглотил моллюска вместе с чернильным облаком?

Чернила проникнут в мозг хищника и вызовут временную потерю памяти
Чернила безвредны при проглатывании
Пищеварительная система хищника будет полностью растворена ферментами, содержащимися в чернилах
Чернила кристаллизуются в желудке хищника, превращаясь в острые структуры
Ответ: чернила проникнут в мозг хищника и вызовут временную потерю памяти
9. Андрей прогулялся по саду и собрал урожай ягод. Однако с точки зрения ботаники не все собранные плоды — ягоды. Помогите Андрею выбрать «настоящую» ягоду:

Ответ: малина
10. Для приготовления салата Маша использовала следующие ингредиенты: томат, огурец, редис, укроп, петрушку, кунжут, лук, чеснок и подсолнечное масло. Представители скольких ботанических семейств были использованы для приготовления салата?
Ответ: 7
11. Из какой части цветка развивается твёрдая оболочка (которую часто называют «скорлупой») у грецкого ореха?

Из цветоложа, которое разрастается и окружает плод
Из части околоплодника
Из видоизменённого эндосперма
Из околоцветника, который видоизменился после оплодотворения
Ответ: из части околоплодника
12. Тараканы — один из разнообразных отрядов насекомых, включающий более 7.5 тысяч видов. Многие из них обитают в дикой природе, но некоторые стали синантропами — спутниками человека. Исторически на территории Руси в жилищах людей встречался чёрный таракан, однако в XVIII веке из Пруссии был завезён рыжий таракан, которого стали называть прусаком. Впоследствии он распространился и сильно потеснил чёрного таракана, так как прусак быстрее размножается и лучше приспособлен к жизни в человеческом жилье. Как называется тип отношений этих видов?
Комменсализм
Нейтрализм
Мутуализм
Конкуренция
Ответ: комменсализм
13. У некоторых животных, например, коз, оленей или овец, зрачки имеют горизонтальную прямоугольную форму. Какое преимущество даёт такая форма зрачка?

Расширяет панорамное зрение по горизонтали
Увеличивает поле обзора по вертикали
Позволяет точнее определять расстояние до объекта
Улучшает ночное зрение за счёт большего раскрытия зрачка
Ответ: Расширяет панорамное зрение по горизонтали
14. Южноамериканская обезьяна императорский тамарин имеет уникальную внешнюю особенность: длинные, загибающиеся вниз белые усы, значительно превосходящие по размеру голову животного. Какую функцию выполняют такие усы?

Обеспечивают лучшее улавливание звуковых вибраций в тропическом лесу
Являются вторичным половым признаком для привлечения партнёра
и демонстрации доминантного статуса
Служат для отпугивания насекомых-кровососов, обитающих в нижнем ярусе леса
Защищают ноздри от попадания пыльцы во время передвижения по лесу
Ответ: являются вторичным половым признаком для привлечения партнёра и демонстрации доминантного статуса
15. У птиц выводкового типа птенцы появляются на свет опушёнными, способны передвигаться уже через несколько часов и могут самостоятельно клевать корм. Выберите выводковую птицу:

Ответ: 1 картинка
16. На рисунке изображен головной мозг животного. Выберите характеристики организма, обладающего таким мозгом:

Пойкилотермное животное
Имеет двухкамерное сердце
Оплодотворение всегда внутреннее
Может иметь плавательный пузырь
Тело всех представителей покрыто чешуей
Ответ: Пойкилотермное животное; имеет двухкамерное сердце; может иметь плавательный пузырь; тело всех представителей покрыто чешуей.
17. Арина сосредоточенно готовилась к контрольной работе за письменным столом, но неожиданно кот Боня запрыгнул на стол, и Арина сильно испугалась. Какие физиологические показатели, скорее всего, увеличат своё значение в организме Арины?
Артериальное давление
Частота сердечных сокращений (пульс)
Частота дыхания
Уровень глюкозы в крови
Активность пищеварительной системы (перистальтика кишечника)
Ответ: Артериальное давление; частота сердечных сокращений (пульс); частота дыхания; активность пищеварительной системы (перистальтика кишечника)
18. Какие животные вскармливают своих детёнышей молоком?

Ответ: 1, 2, 3 картинка
19. Растение сансевиерию, или «щучий хвост», считают растением для ленивых, так как его можно долго не поливать. Выберите верные утверждения о данном растении:
Имеет листья, покрытые толстой восковой кутикулой (кожицей), которая
сильно уменьшает испарение воды
Является суккулентом и запасает воду в своих плотных, мясистых листьях
Имеет очень длинный стержневой корень, поэтому его не нужно поливать
Получает всю необходимую воду из воздуха благодаря особому строению листьев, которые впитывают влагу, как губка
Впадает в состояние покоя (анабиоз) и может полностью прекратить испарять воду

20. В анализе крови пациента выявлено повышенное содержание эритроцитов. Какие причины могут объяснить этот результат?
Проживание в высокогорной местности
Обильное питьё воды в день сдачи анализа
Обезвоживание организма
Хроническая обструктивная болезнь лёгких, при которой нарушена
вентиляция лёгких и организм страдает от хронической гипоксии
Употребление в пищу большого количества свёклы и гранатов
Получить ответы на все задания
21. Используя знания из курса ботаники, установите соответствие между рисунками и фотографиями частей растений.
22. Учитель поручил Арсению разложить готовые микропрепараты для урока биологии. Препараты по ботанике нужно разместить на зелёном подносе, а препараты по зоологии — на белом. Помогите Арсению это сделать.
Получить ответы на все задания
Олимпиада 9 класс Биология ответы
1. Американский палеонтолог Уильям Кинг Грегори, изучая останки ископаемых звероящеров, установил, что кости задней части челюсти пресмыкающихся (сочленовная и квадратная) в процессе эволюции постепенно смещались и уменьшались, пока не превратились в костные структуры современных млекопитающих и человека. Какие?

Ответ: молоточек и наковальня
2. Выберите верное утверждение о ткани человека, микропрепарат которой изображен на рисунке:

Характеризуется самопроизвольными ритмичными сокращениями
В эмбриогенезе развивается из энтодермы
Входит в состав стенок внутренних полых органов и кровеносных сосудов
Состоит из многоядерных структур — симпластов
Ответ: Характеризуется самопроизвольными ритмичными сокращениями
3. Человек хочет взять стакан, но промахивается. После нескольких попыток берёт его и роняет. Во время письма делает много лишних движений. На поражение каких структур головного мозга указывают наблюдаемые симптомы?
Ретикулярной формации
Мозжечка
Моторной зоны коры больших полушарий
Гипоталамуса
Ответ: Мозжечка
4. Какое из необычных морских животных, изображенных на фотографиях, не является рыбой?

Ответ: голубой ангел (3 картинка)
5. Суммарное поле зрения двумя глазами у человека — 220°, а у козы — 340°. Чем обусловлен больший угол обзора у козы?
Вращением глазных яблок вокруг продольной оси независимо друг от друга
Способностью поворачивать голову на 180°
Прямоугольной формой зрачка
Удалением и приближением хрусталика по отношению к сетчатке
Ответ: вращением глазных яблок вокруг продольной оси независимо друг от друга
6. Тело млекопитающего, изображенного на фотографии, покрыто роговыми чешуями. Периодически, садясь около муравейника, зверь растопыривает чешуи. Насекомые забираются под них и кусают животное. Некоторое время зверь терпит, затем быстро прижимает чешуй к телу, раздавливая муравьев. Зачем?

Укусы муравьев стимулируют процессы линьки — обновление роговых чешуй
Запах муравьиной кислоты привлекателен для особей противоположного пола
Муравьиная кислота служит для животного своеобразным допингом
Так животное избавляется от паразитов
Ответ: Так животное избавляется от паразитов
7. Что представляет собой структура, изображенная на рисунке?

Экзокринную железу
Эндокринную железу
Глиальную клетку
Место контакта нейрона и эффекторной клетки
Ответ: место контакта нейрона и эффекторной клетки
8. Какая структура в жизненном цикле яблони развивается в результате тройного последовательного митотического деления мегаспоры?

Ответ: левая точка посередине
9. Зачем гекконы периодически совершают необычные движения языком, как бы облизывая глаза?

Демонстрируют сопернику готовность к нападению
Убирают с поверхности глаза частицы пыли и песка
Прикрывают глаз от яркого солнца
Закрывают один глаз, прицеливаясь другим для прыжка на добычу
Ответ: убирают с поверхности глаза частицы пыли и песка
10. Некоторые птицы (цапли, попугаи, туканы) не имеют копчиковой железы, жирный секрет которой делает оперение других птиц несмачиваемым. Что помогает их перьям оставаться Водонепроницаемыми?
Образование мелкого водоотталкивающего порошка в результате разрушения некоторых перьев по мере их роста
Очень плотное черепицеобразное расположение перьев
Преобладание в рационе рыбы, слизь которой наносится на перья
Наличие в коже сальных желез с воскообразным секретом
Ответ: образование мелкого водоотталкивающего порошка в результате разрушения некоторых перьев по мере их роста
11. Какое влияние на организм оказывает гормон гипофиза вазопрессин?
Стимулирует развитие яйцеклеток и сперматозоидов
Увеличивает почечную реабсорбцию
Усиливает секреторную функцию печени
Усиливает окислительные процессы и расходование белков и жиров
Ответ: увеличивает почечную реабсорбцию
12. Какой гриб не является паразитом?

Ответ: 2 картинка
13. Какое свойство организма млекопитающего изучалось в эксперименте, описываемом следующим изображением?
Репарация
Регенерация
Аутотомия
Анабиоз
Ответ: регенерация
14. Выберите на изображении орган иммунной системы:

Ответ: печень (верхняя точка)
15. Для какого животного характерны органы выделения, изображенные на рисунке?

Для колорадского жука (Leptinotarsa decemlineata)
Для огненной саламандры (Salamandra salamandra)
Для шлемоносного василиска (Basiliscus basiliscus)
Для конской пиявки (Limnatis nilotica)
Ответ: для колорадского жука (Leptinotarsa decemlineata)
16. В связи с гиперфункцией щитовидной железы больному произвели частичную резекцию органа (струмэктомию). После операции у пациента появилась выраженная хрипота. Ветвь какого нерва была случайно повреждена во время операции?
Добавочного
Блуждающего
Тройничного
Поперечного шеи
Ответ: блуждающего
17. Для какого животного характерно развитие с метаморфозом?

Ответ: 2 картинка
18. Выберите верную характеристику клеточного процесса, представленного на снимке:

Осуществляется при участии клеточной стенки
Требует присутствия ионов Са
Нехарактерен для растений
Осуществляется без затрат энергии
Ответ: Требует присутствия ионов Са
19. Какой признак характерен для животного, череп которого изображен на рисунке?

Недоразвитие плаценты
Однопалая конечность
Многокамерный желудок
Втяжные когти
Ответ: втяжные когти
20. Какое растение имеет плод-яблоко?

Ответ: нужно выбрать 2 изображение
21. Какие признаки нехарактерны для растения, у которого в процессе эволюции сформировался цветок, изображенный на рисунке?
Слабое развитие либо отсутствие прорастания зародышевого корешка
Многоклеточный фотосинтезирующий гаметофит
Сетчатое жилкование листьев
Проводящие пучки открытого типа
Вторичное утолщение стебля
Ответ: многоклеточный фотосинтезирующих гаметофит, сетчатое жилкование листьев
22. На основании каких признаков богомола и постельного клопа относят к одному классу?
Зелёная железа
Колюще-сосущий ротовой аппарат
Три отдела тела: голова, грудь, брюшко
Органы дыхания — лёгочные мешки
Органы выделения — мальпигиевы сосуды
Ответ: три отдела тела: голова, грудь, брюшко; органы выделениямальпигиевы сосуды
23. Выберите верные утверждения о фазе сердечного цикла, изображенной на рисунке:

Представляет собой систолу предсердий
Обеспечивает поступление артериальной крови из правого предсердия в правый желудочек
Сопровождается открытием митрального клапана
Продолжается 0.3 с
Продолжается 0.1 с
Ответ: представляет собой систолу предсердий; сопровождается открытием митрального клапана; продолжается 0,1 с
24. Почему детеныши коалы поедают экскременты матери?
Фекалии матери содержат антитела, обеспечивающие естественный иммунитет потомства
В пищеварительный тракт молодых коал попадают микроорганизмы, расщепляющие клетчатку
У детёнышей ещё не прорезались все зубы, они не могут питаться грубой растительной пищей
Экскременты матери содержат быстроусвояемые вещества, обеспечивающие быстрый рост потомства
У детенышей слабо развита мускулатура, они ещё не могут лазить по деревьям и добывать пищу
Ответ: в пищеварительный тракт молодых клал попадают микроорганизмы, расщепляющие клетчатку; фекалии матери содержат антитела, обеспечивающие естественный иммунитет потомства
25. Чем характеризуется изображенная экосистема?

Резким колебанием теплового режима
Низкой плотностью среды
Низкой прозрачностью среды
Неравномерным распределением организмов
Пониженным содержанием кислорода
Ответ: неравномерным распределением организмов, пониженным содержанием кислорода
26. Почему пчеловоды переживают из-за массового размножения бабочек-огнёвок?
Огнёвки откладывают яйца в тело личинок пчел, приводя к их гибели
Огнёвки конкурируют с пчелами за цветочный нектар
Личинки бабочки поедают мёд, пергу, воск сот
Личинки бабочки повреждают расплод пчел
При окукливании гусеницы покрывают соты шёлком

27. Чем сопровождается воспалительный процесс, возникающий при попадании в кожу человека инородного тела?
Увеличением количества лейкоцитов крови
Расширением кровеносных сосудов кожи
Активным фагоцитозом
Повышением общей вязкости крови
Повышением артериального давления
Получить ответы на все задания
28. Зачем цапля, стоя на мелководье, периодически расправляет крылья, создавая вокруг себя обширную тень?
Стряхивает насекомых паразитов
Привлекает добычу
Привлекает особей противоположного пола
Защищается от ослепления солнечными бликами на поверхности воды
Разминает мышцы перед полётом
29. Какие животные НЕ относится к синантропным?

30. На рентгенограмме изображена одна из патологий позвоночника человека. Каковы могут быть её причины?
Неудачно поднятый груз
Привычка носить вес в одной руке
Недостаток в организме витамина Д
Длительное пребывание в неправильной позе
Мышечная дистрофия

31. Установите соответствие между микропрепаратами и формами бактерий.
32. Установите соответствие между моллюсками и экологическими группами, к которым они относятся.
33. Установите соответствие между функциями органоидов клетки и их электронными микрофотографиями.
34. Николай решил рассчитать скорость кровотока в капиллярах ногтевого ложа (V, м/с). Сначала он измерил длину ногтевой пластинки большого пальца кисти от корня до её вершины (S, м) — это путь, который проходит кровь. Затем нажал указательным пальцем на ноготь большого пальца так, чтобы он побелел и кровь вышла из сосудов ногтевого ложа. Убрав указательный палец, мальчик измерил время (t, c) до полного покраснения ногтя. Оно составило 30 с. Скорость кровотока в капиллярах ногтевого ложа Николай рассчитал по формуле. Используя рисунок, повторите расчёты Николая и определите скорость кровотока в аорте, если известно, что суммарный просвет капилляров в 1000 раз больше, чем просвет порты. Ответ выразите в м/с.
35. Учёные планируют полевой эксперимент «Лисий рай». На ограниченной территории планируется высадить яровую пшеницу, к моменту созревания запустить 15 взрослых лисиц и мышей в количестве, достаточном для их питания. Продуктивность пшеницы за сезон составляет 3 т/га, в среднем лисе необходимо 500 г пищи в день. Других источников питания и конкурентов у консументов нет. При этом в пищевой цепи при переходе с одного трофического уровня на следующий поступает только 10% энергии (массы), накопленной предыдущим уровнем. Какой минимальный размер должна иметь пробная площадка для данного эксперимента? Ответ выразите вгектарах, округлите до десятых.
Получить ответы на все задания
Олимпиада 10 класс Биология ответы
Задание 1. На иллюстрации показан процесс работы микробиолога с использованием микробиологической петли. Сначала инструмент подвергается стерилизации. Затем микробиологическая петля погружается в пробирку с исследуемой культурой микроорганизмов и культура переносится на стерильную чашку Петри для последующего анализа.

Для каких целей применяется данная техника нанесения культуры на чашки Петри?
Для получения красивого рисунка
Для получения в конечном итоге равномерного распределения микроорганизмов по чашке Петри
Для получения в конечном итоге смешанной культуры
Для получения одиночных колоний
Ответ: Для получения одиночных колоний
Задание 2. Для некоторых насекомых характерна стадия личинки.

Личинка какого насекомого представлена на фото?
Бабочки
Пчелы
Стрекозы
Майского жука
Ответ: Стрекозы
Задание 3. На картинке схематично изображён поперечный срез красной водоросли фурцеллярии, из которой получают полисахарид типа каррагинана — фурцелларан, также используемый в качестве загустителя при изготовлении мясных изделий, мармелада, зефира и т. д. Таллом фурцеллярии состоит из псевдоткани, водоросль выглядит как листостебельное растение, но на самом деле представлена переплетением нитей.

Какой организм имеет подобное строение?
Гриб подосиновик
Плаун булавовидный
Кукушкин лён
Папоротник рода щитовник
Ответ: Гриб подосиновик
Задание 4. На дне Тихого океана, вблизи глубоководных гидротермальных источников, живёт уникальный червь — Paralvinella hessleri. Этот организм способен выживать в экстремальных условиях, где вода насыщена тяжёлыми металлами и металлоидами. Он превращает мышьяк внутри своих клеток в относительно безвредный минеральный комплекс, соединяя его с сероводородом. Образующееся вещество имеет характерный золотистый цвет. Этот процесс называется внутриклеточной биоминерализацией. В отличие от биоминерализации у других животных (например, при образовании раковин или скелетных структур), он направлен не на построение опорных тканей, а на химическую детоксикацию — превращение опасных веществ в безвредные.

Выберите верное утверждение:
Организмы в экстремальных условиях всегда избегают накопления тяжёлых металлов
Живые организмы способны использовать химически активные токсины как основной источник углерода для поддержания метаболизма
Некоторые организмы способны превращать яды во внутриклеточные безопасные структуры
Тяжёлые металлы необходимы всем формам жизни как кофакторы ферментов
Ответ: Некоторые организмы способны превращать яды во внутриклеточные безопасные структуры
Задание 5. Нередко летом удаётся найти небольшие, сладкие, но очень колючие огурцы. Изначально растение дикий огурец имело более острые и длинные шипы, которые защищали незрелые плоды от преждевременного съедания животными. После созревания они отпадали, и то, что сейчас покрывает кожицу плода, и есть форма зрелого огурца. Со временем, в ходе селекции, удалось избавиться от колючих шипов, но всё же бугорки на огурце остались.
Какой термин наиболее подходит для описания таких колючек‑бугорков у современного огурца?
Переходная форма
Рудименты
Редуценты
Атавизмы
Ответ: Рудименты
Задание 6. На рисунке представлен процесс, связанный со взаимодействием гриба и растения.

Для какого гриба характерен данный способ взаимодействия?
Для белого гриба
Для аспергилла
Для пеницилла
Для фитофторы
Ответ: Для фитофторы
Задание 7. Примитивные двудольные растения, такие как магнолия, сохранили архаичные (относительно других представителей класса) признаки строения цветка и плода.

Какой признак указывает на примитивное (древнее) строение растения?
Цветок с чётким разделением на чашечку и венчик
Плод — многолистовка
Чашелистики и лепестки, сросшиеся между собой
Цветок пятичленного типа с расположенными в одном круге частями
Ответ: Плод — многолистовка
Задание 8. У рыб встречаются разные типы чешуи, отличающиеся по строению, прочности и функциям.
Плакоидная чешуя (у акул и скатов) — плотные костные пластинки с острыми кончиками, похожие на зубы.
Ганоидная чешуя (у панцирных щук, осетров) — твёрдая, ромбовидная, часто покрыта слоем ганоина (род эмали).
Циклоидная чешуя (у лосося, карпа) — гладкие округлые пластины.
Ктеноидная чешуя (у окуня, судака) — похожа на циклоидную, но с зазубренными краями по заднему краю.
Какая чешуя рыбы‑жертвы представляет наибольшую опасность для хищника?

Ответ: плакоидная
Задание 9 Дана фотография бактерии, полученная с помощью просвечивающей электронной микроскопии. Клетка предположительно принадлежит к роду бацилл.

Какая структура показана стрелкой?
Спора
Капля включений
Газовая вакуоль
Нуклеоид
Ответ: Спора
Задание 10. Какая часть тела содержит наибольшее количество сенсорных окончаний на единицу площади?
Волосяная луковица
Подмышечные впадины
Кончики пальцев
Шея
Ответ: Кончики пальцев
Задание 11. На фотографии изображён ландыш майский (Convallaria majalis) — многолетнее растение семейства спаржевых. Его особенность, помимо красоты, в содержании веществ, которые оказывают ингибирующее действие на Na+/K+‑АТФазы кардиомиоцитов.

Для каких целей человек может использовать такие вещества?
Для улучшения сна
Для лечения аритмии
Для повышения интенсивности сокращения мышц на силовых тренировках
Для лечения разрыва мышц

Задание 12. После экспедиции в Долину гейзеров на полуострове Камчатка учёные привезли образцы воды. В лаборатории в них были обнаружены термофильные микроорганизмы, способные существовать при высоких температурах (около 80 ∘C). Из этих организмов были выделены термоустойчивые ферменты, сохраняющие активность даже в экстремальных условиях.
В какой области прикладной науки такие ферменты нашли или могут найти наибольшее применение?
Полимеразная цепная реакция (ПЦР)
Производство жаропрочных пластмасс
Стерилизация молока
Изготовление ряженки
Получить ответы на все задания
Задание 13. На рисунке представлено строение мозга человека. Выберите область, отвечающую за зрение:

Задание 14. К какому семейству относится данное растение?

Яснотковые
Паслёновые
Розоцветные
Астровые
Задание 15. Капсаицин — вещество, содержащееся в плодах острого перца. Оно вызывает жжение при соприкосновении со слизистыми оболочками животных, отпугивает многих травоядных и делает плод «несъедобным» для большинства млекопитающих. При этом некоторые птицы спокойно поедают острые плоды и не ощущают жжения.
Выберите наиболее вероятное объяснение:
Жжение от капсаицина необходимо, чтобы стимулировать пищеварение у животных для более быстрого распространения семян
Птицы поедают острый перец, потому что у них быстрый метаболизм и капсаицин быстро инактивируется
Капсаицин создан для защиты от всех животных, но у птиц эволюционно выработался иммунитет к нему
У птиц нет рецепторов, которые реагируют на капсаицин, таким образом, именно они распространяют семена, поедая их
Получить ответы на все задания
Олимпиада 11 класс Биология ответы
Задание 1. График на рисунке отображает скорость роста популяции организмов. В какой части графика прирост численности максимален?

Ответ: 2
Задание 2. На рисунках изображены представители планктона, панцири которых содержат определённые химические элементы.

Какие?
А и Б содержат кальций
А — кальций, Б — кремний
А — кремний, Б — кальций
А и Б содержат кремний
Ответ: А — кальций, Б — кремний
Задание 3. Выберите срез органа голосеменного растения:

Ответ: 1
Задание 4. Плод какого растения с точки зрения ботаники принадлежит к той же категории, что и плод томата?

Ответ: 4
Задание 5. На фотографии изображено развитие и старение сои.

Какой растительный гормон играет важную роль на протяжении двух последних стадий?
Этилен
Ауксин
Цитокинин
Гиббереллин
Ответ: Этилен
Задание 6. Отметьте сердце на изображении дафнии:

Ответ: 2
Задание 7. Выберите верное утверждение о мочеполовой системе птиц:
Основным органом выделения у птиц, в отличие от млекопитающих, являются не почки, а специальные солевые железы, расположенные в клюве; это позволяет эффективно выводить избыток солей, потребляемых с пищей и водой
У птиц отсутствует мочевой пузырь, а мочеточники открываются в клоаку; это позволяет экономить воду за счёт обратного всасывания её из мочи в клоаке, что критически важно для обитателей засушливых регионов
У птиц отсутствует мочевой пузырь, а конечным продуктом азотистого обмена является не растворимая мочевина, а труднорастворимая мочевая кислота, что позволяет резко сократить объём выделяемой воды и массу выделительной системы для облегчения полёта
У птиц мочеточники открываются непосредственно в уретру, а не в клоаку; это разделяет пути вывода мочи и кала, обеспечивая гигиеничность гнезда, что является важным элементом заботы о потомстве
Ответ: У птиц мочеточники открываются непосредственно в уретру, а не в клоаку; это разделяет пути вывода мочи и кала, обеспечивая гигиеничность гнезда, что является важным элементом заботы о потомстве
Задание 8. На фотографии изображён орган человеческого тела.

Выберите верную характеристику этого органа:
Все мышцы органа иннервируются единственным черепным нервом подъязычным (XII пара), что обеспечивает простоту и надёжность управления его сложными движениями
Этот орган имеет самую сложную и развитую поперечнополосатую мускулатуру в организме, что позволяет осуществлять тончайшие произвольные движения, необходимые для членораздельной речи
Нитевидные сосочки органа ороговевают и образуют шероховатую поверхность, которая функционирует как тёрка для соскабливания мяса с костей добычи, что является атавизмом, унаследованным от хищных предков
У человека, в отличие от других млекопитающих, этот орган активно участвует в терморегуляции, так как его обильное кровоснабжение и большая площадь поверхности позволяют эффективно отводить избыточное тепло за счёт испарения слюны
Ответ: Нитевидные сосочки органа ороговевают и образуют шероховатую поверхность, которая функционирует как тёрка для соскабливания мяса с костей добычи, что является атавизмом, унаследованным от хищных предков
Задание 9. Известно, что скелетные мышцы человека состоят из волокон разного типа (окислительных и гликолитических), которые значительно различаются по количеству и свойствам митохондрий.
Выберите характеристику мышц ног высококвалифицированного марафонца, отличающую их от мышц спринтера:
Большая активность ферментов анаэробного гликолиза в матриксе митохондрий
Меньшее количество крист в митохондриях для ускорения диффузии ATP
Большая плотность митохондрий и более интенсивный цикл Кребса
Преобладание процессов окислительного фосфорилирования в пероксисомах
Ответ: Большая плотность митохондрий и более интенсивный цикл Кребса
Задание 10. Среди историков науки существует легенда о том, что дамы высшего света в XVIII веке боялись выходить на улицу в сумерках из-за летучих мышей. Высокие сложные причёски (например, фонтанж) якобы были «невидимы» для эхолокатора мышей, из-за чего те могли запутаться в волосах.
Какое физическое свойство сложной причёски с биологической точки зрения могло бы сделать её «невидимой» или плохо различимой для эхолокационной системы насекомоядных летучих мышей?
Сигналы эхолокатора летучих мышей настроены на распознавание хитинового панциря насекомых; кератин человеческих волос имеет принципиально иную акустическую проводимость, которую сонар мышей не мог корректно интерпретировать
Светлый цвет пудры, которой обильно посыпали причёски, сильно отражает остаточный солнечный свет в сумерках; это ослепляет летучих мышей, чьи глаза были адаптированы к темноте, и заставляет их терять ориентацию
Мелкопористая, сложная и упругая структура причёски эффективно поглощает и рассеивает ультразвуковые сигналы мышей, не возвращая им достаточного для детализации эхосигнала, что делает её акустически невидимой
Причёска, обильно смазанная жирами и восками, выделяет летучие органические соединения, которые маскируют человеческий запах и перекрывают насекомоядным мышам обонятельный поиск добычи, дезориентируя их
Ответ: Мелкопористая, сложная и упругая структура причёски эффективно поглощает и рассеивает ультразвуковые сигналы мышей, не возвращая им достаточного для детализации эхосигнала, что делает её акустически невидимой
Задание 11. Фукус пузырчатый (Fucus vesiculosus) — вид бурых водорослей, обычный обитатель литорали — приливно‑отливной зоны. Характерной особенностью этого вида являются парные газовые пузыри (пневмоцисты), расположенные по обе стороны от срединной жилки таллома.

Какую экологическую роль играют газовые пузыри фукуса пузырчатого, обеспечивающая его адаптацию к специфическим условиям среды обитания?
Пузыри используются для запасания кислорода, образующегося в процессе фотосинтеза, для последующего использования его в дыхании в темное время суток
Пузыри обеспечивают плавучесть таллома, чтобы в прилив, когда водоросль погружена в воду, она занимала вертикальное положение в хорошо освещённой толще воды
Пузыри выполняют защитную функцию, делая таллом более жёстким и менее доступным для поедания мелкими растительноядными организмами
Пузыри служат резервуаром для запаса питательных веществ (полисахаридов) на период отлива, когда фотосинтез невозможен

Задание 12. Муха цеце (род Glossina) является переносчиком трипаносом — паразитов, вызывающих смертельную сонную болезнь у животных и человека. Цеце нападает на многих крупных млекопитающих в саваннах Африки, однако зебры остаются одним из её наименее предпочитаемых хозяев. Считается, что полосатая окраска зебры является адаптацией, снижающей риск нападения этого кровососа.
Какой механизм лежит в основе того, что полосатая окраска зебры защищает её от нападения мухи цеце?
Полосатый окрас эффективно маскирует зебру в высокой траве саванны, визуально разбивая её силуэт, что делает её менее заметной для мухи цеце
Чередование тёмных и светлых полос создаёт оптическую иллюзию, которая дезориентирует муху цеце на близком расстоянии, нарушая процесс посадки на кожу животного
Светлые полосы сильнее отражают поляризованный свет, а тёмные — поглощают его; эта неестественная картина поляризации света непривлекательна для мух цеце, которые ищут добычу по поляризованному свету, отражённому от шкур животных
Полосы создают конвекционные потоки воздуха вдоль тела зебры, которые рассеивают запахи (CO2, пот), затрудняя мухе цеце поиск хозяина по химическим сигналам
Получить ответы на все задания
Задание 13. Выберите верную характеристику процесса, изображённого на фотографии:

Для изоляции цитоплазм этих клеток необходимо создание срединной пластинки
Этот процесс может быть нарушен при обработке клеток веществами, ингибирующими полимеризацию тубулина
Розовым цветом окрашены вакуоли с твёрдыми включениями
Для клеток характерно наличие клеточной стенки с многочисленными выростами
Получить ответы на все задания
Задание 14. На фотографии изображены клетки яичников моли. Синим цветом обозначены ядра клеток.

Выберите название вещества, которое на картинке подкрашено серым цветом:
Миозин
Актин
Фиброин
Тропонин
Получить ответы на все задания
Задание 15. На фото показаны флуоресцентно окрашенные клетки эмбриона цыплёнка.

Частью какой системы организма станут эти клетки?
Нервной
Кровеносной
Половой
Выделительной
Получить ответы на все задания
Ответы на ВсОШ бесплатно, мы публикуем в нашем телеграм канале — https://t.me/sirius_otveti_olimpiada



